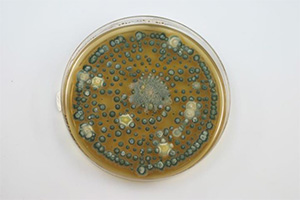
Neuke, J.Th. Schädlingsbekämpfung

Unser Leistungsangebot:
Schädlingsbekämpfung
- vorbeugende Schädlingsbekämpfung
- Rattenbekämpfung
- Mäusebekämpfung
- Käferbekämpfung
- Schabenbekämpfung
- Wanzenbekämpfung
- Ameisenbekämpfung
- Mottenbekämpfung
- Fliegenbekämpfung
- Taubenabwehr
- Flohbekämpfung
- Mardervergrämung
- Schimmelsanierung
- Wespennotdienst
Trinkwasserproben
Trinkwasseruntersuchung nach der neuen deutschen Trinkwasserverordnung vom 1. November 2011. Die Reinhaltung und Überprüfung des Trinkwassers ist durch die Trinkwasserversorgung (Abk. TrinkwV oder TVO) geregelt.
Die Überprüfung des Trinkwassers gehört zu den verantwortungsvollen Aufgaben, die einen wichtigen Beitrag zur Gesundheit leisten können, z. Bsp. in Gesundheitsbereich (Krankenhäusern, Seniorenheimen, Pflegeeinrichtungen, Tageseinrichtungen usw.)
Fleisch und Fleischverarbeitung
Bäckereien, Süßwarenhersteller
Großküchen und Catering Services
Haushalten, Schulen, Kindergärten und Hausverwaltungen sollten regelmäßige Trinkwasseranalysen durchgeführt werden, um eine gute Qualität zu gewährleisten.

Abklatschproben
Abklatschproben für die Überwachung der Hygiene als auch zur Qualitäts- kontrolle in vielen Branchen, z. Bsp.: Gesundheitsbereich (Kranken- häusern, Seniorenheimen, Pflege- einrichtungen, Tageseinrichtungen usw.)
Fleisch und Fleischverarbeitung
Bäckereien, Süßwarenhersteller
Großküchen und Catering Services
Holz- und Bautenschutz (Sanierung)
- Holzschutz
- Fassadensanierug
- Fassadenimprägnierung
- Betonsanierung
- Beschichtung
- Keller - Innenabdichtung
- Keller - Außenabdichtung
- Dauerelastische Fugenabdichtung
- Grafitti- Entfernung
- Grafitti- Schutz
Facility - Service
- Hausmeisterdienste
- Dachrinnenreinigung
- Fassadenreinigung
HACCP & LMHV
Das HACCP – Konzept (Hazard Analysis Critical Control Point) wurde in den USA entwickelt. Es bedeutet übersetzt „Risikoanalyse und Überwachung der kritischen Steuerungspunkte“ und soll mithelfen die Einhaltung der Hygienevorschriften im täglichen Betrieb zu gewährleisten.
LMHV ist die Abkürzung für Lebensmittelhygiene – Verordnung. Die aktuelle gültige Fassung war von 1997. Mit der LMHV wurde die Richtlinie 93/43/EWG des Europäischen Rates in nationales Recht umgesetzt. Die zentralen Anliegen der LMHV sind damit die Sicherstellung einheitlicher Hygienestandards in der Europäischen Union sowie die Einführung des international anerkannten HACCP – Konzeptes. Ab 01.01.2006 gilt die neue EU Lebensmittel- Verordnung und das HACCP.
Wir unterstützen Sie von Anfang an, um das HACCP – Konzept in Ihrem Bereich unter betriebwirtschaftlichen Gesichtspunkten „einzurichten, zu ergänzen und zu begleiten“.
Dazu bieten wir die:
- Begutachtung und Konzepterstellung,
- Einrichtung eines gezielten Monitoringsystems,
- Schulung des zuständigen Personals,
- Bekämpfung mit zugelassenen Wirkstoffen,
- Dokumentation (auch für Ihre Unterlagen)
Umgesetzt wird es von uns bereits in:
- Schulen
- Kindergärten
- Heimen
- Krankenhäusern
- Hausverwaltungen
- Industrie
- Lebensmittelindustrie
- Landwirtschaft
- öffentlichen- und privaten Auftraggebern


